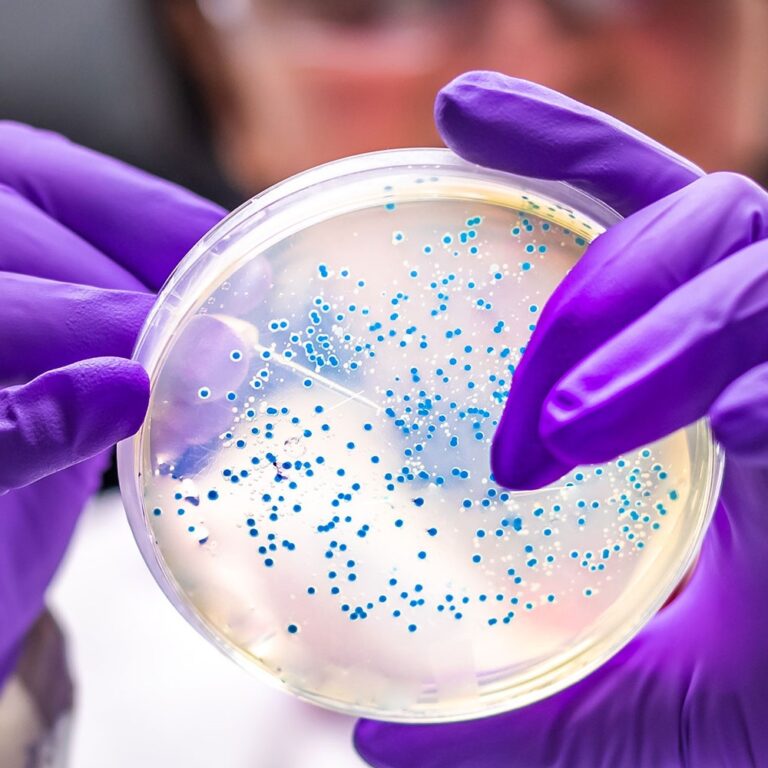
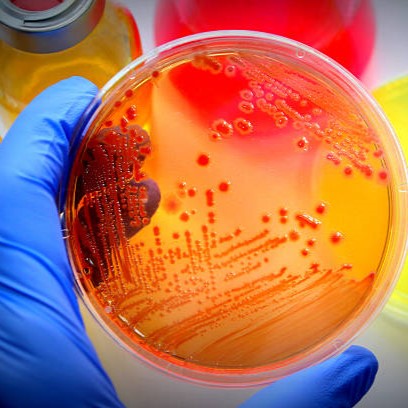

Generamos experiencias de servicio humanizado y atención segura
Nos apoyamos en las necesidades de las personas que confían en nosotros. Contamos con pruebas de laboratorio realizadas con equipos de última tecnología, lo que garantiza resultados confiables.
NUESTROS SERVICIOS
La SOCIEDAD MEDICA CLINICA MAICAO, cuenta con un amplio portafolio de servicios para los usuarios quienes con un gran equipo interdisciplinario trabajan diariamente para brindar lo mejor, en este servicio pueden encontrar:

GESTION PRE- TRANSFUSIONAL
La gestión pre-transfusional en el laboratorio es el conjunto de procedimientos inmunohematológicos y administrativos realizados antes de una transfusión para garantizar su seguridad, compatibilidad y eficacia.
Prueba de Compatibilidad.
Rastreo de Anticuerpos.
Combs Direct.

BIOLOGIA MOLECULAR
Se especializa en la detección, análisis y cuantificación de ADN o ARN para diagnosticar enfermedades infecciosas, genéticas y oncológicas con alta precisión.
- PCR Mycobacterium.
- Cultivo para Mycobacterium.
- Identificación simultanea de múltiples patógenos.
- Identificación de genes de resistencia para múltiples patógenos.
- Detección virus del papiloma Humano.

INMUNOLOGÍA
Se analiza el sistema inmunitario en muestras de sangre (suero) para diagnosticar infecciones, alergias, enfermedades autoinmunes y deficiencias.
- ASTO.
- RA- TEST.
- Hepatitis A.
- Hepatitis B.
- Hepatitis C.
- Sífilis.
- Entre otros.

LABORATORIO CLINICO AUTOMATIZADO
Un laboratorio clínico automatizado utiliza robótica y software avanzado para procesar muestras biológicas con mínima intervención humana.
- Toma de muestras.
- Inmunoquímica y pruebas especiales.
- Hematología automatizada.
- Inmunología.
- Coagulación.

UNIDAD TRANSFUNSIONAL
Una unidad transfusional (UMT) es el servicio médico-técnico hospitalario que gestiona la terapéutica transfusional, asegurando el suministro seguro y oportuno de sangre y sus componentes.
- Prueba de compatibilidad.
- Hemoclasificación.
- Rastreo de anticuerpos.
- Coombs Directo.
- Viscoelasticidad De La Sangre.

UROANALISIS
Es un estudio de laboratorio fundamental que evalúa física, química y microscópicamente la orina para detectar enfermedades renales, hepáticas, infecciones del tracto urinario, diabetes y otros trastornos metabólicos.
- Parcial de Orina.
PARASITOLOGIA
La parasitología en el laboratorio clínico es la rama de la microbiología encargada de identificar parásitos en muestras biológicas para diagnosticar infecciones parasitarias.
Coprológico.
Coproscópico.
Coprológico Seriado.
Sangre oculta.

HEMATOLOGÍA
Esta área estudia la sangre y sus trastornos, abordando células sanguíneas, coagulación y enfermedades como anemias o leucemias.
- Hemograma Automatizado.
- VSG.
- E.S.P.
- Reticulocitos.
- Hemoclasificación.

COAGULACIÓN
Este análisis evalúa la capacidad de la sangre para formar coágulos y detener hemorragias, analizando plaquetas, factores de coagulación y vasos sanguíneos.
- PT.
- PTT.
- INR.
- Fibrinógeno.
- Dímero D.
- Viscoelasticidad De La Sangre.

INMUNOQUÍMICA Y PRUEBAS ESPECIALES
Se utiliza reacciones antígeno-anticuerpo para detectar y cuantificar sustancias específicas con alta sensibilidad, siendo crucial para el diagnóstico de enfermedades autoinmunes, alergias, cáncer y trastornos hormonales.
- Perfil Lipídico.
- Perfil Renal.
- Perfil Tiroideo.
- Perfil Hepático.
- Perfil Infeccioso.
- Hb Glicosilada.
- Entre otros..
MICROBIOLOGÍA
Esta área identifica microorganismos como bacterias y virus responsables de infecciones, además de determinar la sensibilidad a ciertos medicamentos.
- Urocultivo.
- Hemocultivo.
- Cultivo de diferentes muestras.
- Espermograma.
- Espermocultivo.
- Cultivo para Hongos.
- Frotis Vaginal.
- Frotis Uretral.
EQUIPO TECNOLÓGICO

















GRUPO INTERDICIPLINARIO



INFORMACIÓN Y EMERGENCIAS
PBX (605) 725 65 00
DIRECCIÓN
TRABAJA CON NOSOTROS


